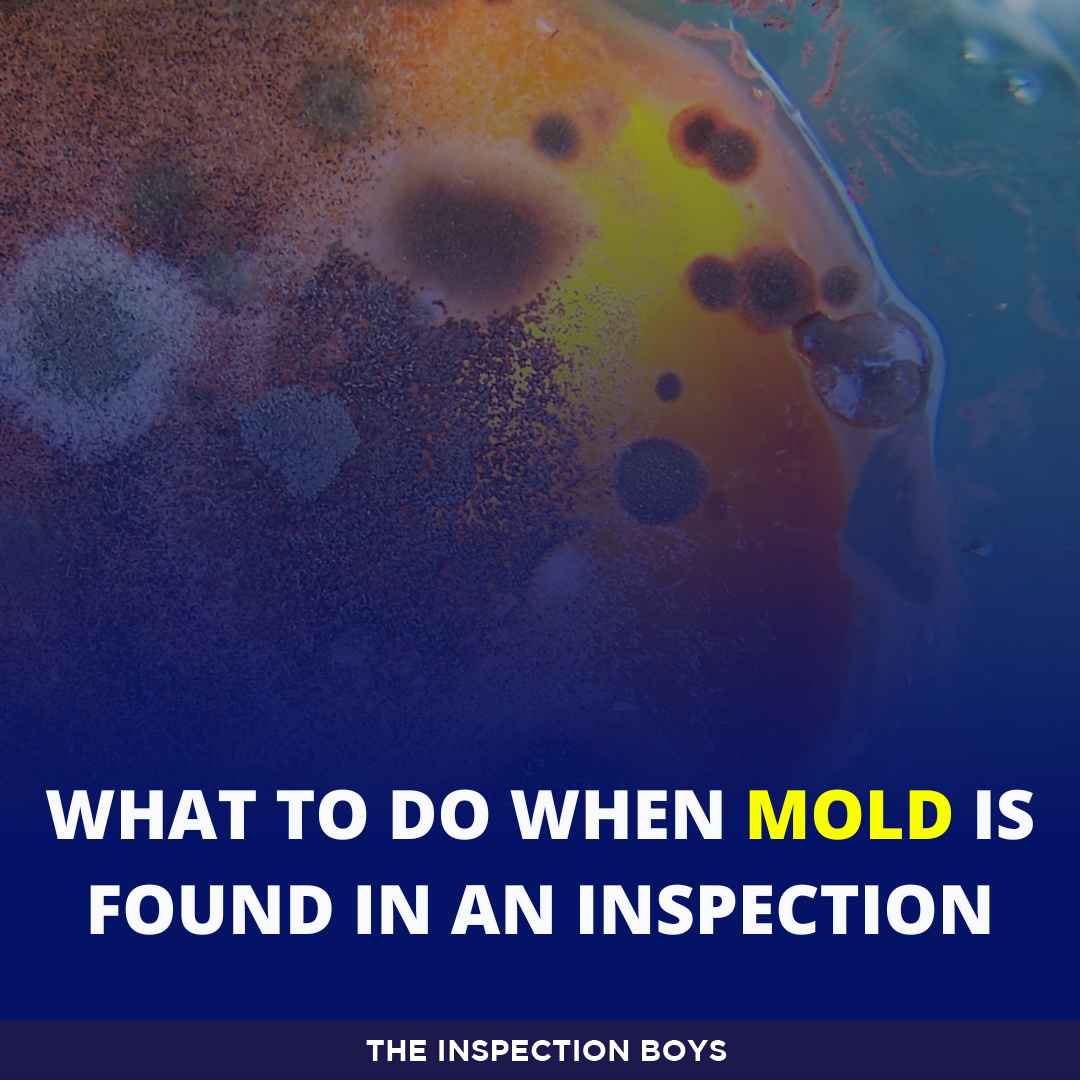

Maintain The Ideal Water Parameters With Einstapp’s Focused Calculator
À propos de moi Maintain The Ideal Water Parameters With Einstapp’s Focused Calculator
Ill be the first to put up with it. My first attempt at a community tank was a disaster. I walked into the local pet store, wise saying those vivid neon blues and fiery oranges, and basically had a ”shut up and endure my money” moment. I didn’t have a plan. I just had a 20-gallon tank and a dream. Three weeks later, my lovely aquatic oasis looked more as soon as a crowded subway car at hurry hour. The water was cloudy, the fish were nipping at each others fins, and my ammonia levels were spiking harder than a tech store in the 90s. Thats following I realized the difficult way: fish tank stocking isn’t roughly how many fish can physically fit in the water. Its roughly biological balance. If Id had the Einstapp Fish Tank Stocking Calculator, I could have avoided the heartbreak and the expensive mistakes. It is the ultimate online fish stocking tool for anyone tired of playing a guessing game as soon as their pets’ lives.
The Lethal Myth of the One-Inch Rule
Weve all heard it. The ”one inch of fish per gallon” rule is the most persistent lie in the hobby. Its simple, its simple to remember, and its as regards unquestionably wrong. Think about it. Does a five-inch Oscar develop the thesame amount of waste as five one-inch Neon Tetras? Not even close. One is a slender, low-impact fish; the extra is basically a swimming trash disposal. If you follow that obsolescent rule, youre inviting aquarium glass calculator overcrowding back you even get your fish home. The Einstapp Fish Tank Stocking Calculator throws that believe to be out the window. It uses a much more later metric: the bio-load management index. This considers the accumulation of the fish, their metabolic rate, and even their typical protest levels. I used to think my Molly was just ”busy,” but the calculator pointed out that Mollies have a serious bio-impact compared to supplementary fish of the similar size. Avoid crowding in your fish tank by actually knowing what is taking place under the surface.
Understanding the Hidden Variable: Ghost Volume
Here is something most people forget. with you buy a 40-gallon tank, you don’t actually have 40 gallons of water. considering you accumulate three inches of substrate, forty pounds of Seiryu stone, and a massive fragment of driftwood, you might single-handedly have 32 gallons left. This is what I call ”Ghost Volume.” Many hobbyists calculate their stocking based on the empty tank size, leading to immediate aquarium overcrowding. One of the coolest features of the Einstapp Fish Tank Stocking Calculator is the displacement algorithm. You can input your estimated hardscape weight, and it calculates your legitimate water volume. It’s a game-changer. It helps preserve water parameter stability because it knows you have less water to dilute the nitrates than you think you do. Its that new increase of precision that makes it more than just a basic calculator.
Predicting Personalities following Tropical Fish Compatibility
I taking into consideration tried to put a pair of Dwarf Gouramis in a tank subsequent to some flashy fancy guppies. I thought theyd look great together. I didn’t pull off that the Gouramis would look those flowing guppy tails as an manipulation to their certainly existence. Within forty-eight hours, my guppies were hiding at the back the intake sponge, terrified. The Einstapp Fish Tank Stocking Calculator doesn’t just see at nitrogen; it looks at tropical fish compatibility. It has a built-in ”Social distress Index” for alternative species. It warns you if youre pairing an brusque fin-nipper once a slow-moving long-finned species. Its similar to a dating app for fish, but otherwise of finding love, you’re preventing a murder vagueness in your blooming room. Fish tank health is as much virtually mental goodwill as it is roughly tidy water. stress is the number one killer of captive fish, often leading to Ich or velvet. Using a tool to preventing fish stress through proper social pairing is non-negotiable for a flourishing tank.
The Nitro-X Algorithm: A supplementary Frontier in Bio-load Management
Lets chat virtually the tech. Most calculators use obsolete tables from the 80s. The Einstapp Fish Tank Stocking Calculator uses something called the Nitro-X Algorithm. This is a proprietary system that predicts the top ammonia and nitrite spikes based on your specific species and feeding habits. It asks you how often you feedonce a day? Twice? complete you use flakes or frozen? It sounds as soon as overkill, but it isn’t. High-protein sedated foods create a much later bio-load than simple flakes. The calculator adjusts your maximum stocking limit based upon these inputs. This helps you comprehend your aquarium filtration capacity in a way a encyclopedia adding up never could. If youre pushing the limits, the tool will literally say you, ”Hey, your filter can’t handle this many stifling eaters.” It forces you to be honest taking into account yourself practically your allowance routine.
Don’t Forget the Aquarium Filtration Capacity
Your filter is the lung of your aquarium. But heres the kicker: just because a filter says ”up to 50 gallons” doesn’t intention it can handle a 50-gallon tank packed later than Goldfish. Goldfish are invincible waste producers. The Einstapp Fish Tank Stocking Calculator allows you to input your specific filter model or its GPH (Gallons Per Hour) rating. It next cross-references this taking into consideration your planned inhabitants. Its the best showing off to avoid crowding in your fish tank by ensuring your mechanical and biological filtration can keep up. Ive seen people double their filtration and think they can double their fish. Thats a dangerous game. Its not just practically removing waste; its virtually oxygen argument and swimming space. The calculator keeps you within the danger-free zone.
The Impact of Surface area and Gaseous Exchange
A tall, narrow ”hexagon” tank has a interchange carrying talent than a broad ”breeder” tank, even if they retain the perfect thesame volume of water. Why? Surface area. Oxygen enters the water at the surface. Carbon dioxide leaves at the surface. A tall tank has less surface area for gaseous exchange. If you collection it once a gratifying rectangular tank, your fish will be gasping for let breathe at the top by week two. The Einstapp Fish Tank Stocking Calculator takes tank dimensions into account. It prioritizes the ”footprint” greater than the ”height.” This is crucial for fish tank health. I recall helping a pal who had a ”column” tank full of Barbs. They were always sluggish. We ran her specs through the Einstapp Fish Tank Stocking Calculator, and it flagged a 40% oxygen deficit for the bottom-dwellers. We swapped some fish out, and the alter was instant. They went from lethargic to full of zip in hours.
Managing the accumulation Potential of ”Juvenile” Fish
Weve all seen themthose attractive little one-inch iridescent sharks at the pet shop. They see absolute for a 29-gallon tank, right? Wrong. They be credited with into three-foot long monsters. Many beginner hobbyists accrual their tanks based on the size of the fish today. The Einstapp Fish Tank Stocking Calculator uses maximum adult sizes in its database. It won’t let you accrual a baby Oscar in a small tank without giving you a loud red rebuke sign. This prevents ”stunting,” a horrific condition where a fishs body stops growing because of cramped quarters, but its internal organs keep growing. Its pining and reduced their lives. By using this online fish stocking tool, you are committing to the long-term well-being of your aquatic pets.
Water Parameter Stability: The Buffer Zone
The more fish you have, the thinner your margin for error. In a lightly stocked tank, if you forget a weekly water regulate by two days, nothing happens. In an overcrowded tank, those two days can be a death sentence. The ammonia builds occurring faster than the bacteria can process it, the pH crashes, and the cumulative nitrogen cycle collapses. The Einstapp Fish Tank Stocking Calculator helps you visualize this ”buffer zone.” It suggests a stocking level that keeps your water parameter stability in the green, even if you miss a beat. I in the manner of to call it the ”vacation insurance.” If I go away for a weekend, I don’t desire to arrive encourage to a crashed tank. By in imitation of the calculator’s conservative estimates, I know my fish are safe.
Using the Calculator for Shrimp and Invertebrates
Don’t think these rules and no-one else apply to fish. Snails and shrimp have a bio-load too. People think vagueness Snails are ”cleaners.” In reality, they are supreme waste producers. They might eat algae, but they direction it into a lot of ammonia certainly quickly. The Einstapp Fish Tank Stocking Calculator includes a combine list of invertebrates. It helps you locate the right gallon-to-fish ratio bearing in mind you start mixing species. It prevents you from count twenty ”cleaner” snails that end taking place making the tank dirtier than it was before. For my reef-keepers, this report as well as accounts for corals that might have stinging tentacles, ensuring you don’t over-stock your sand bed.
Final Thoughts: Be a liable Fish Keeper
Owning an aquarium is a huge responsibility. You are the god of that little ecosystem. If you fail, they die. Its that simple. Often, we acquire carried away by the aesthetics and forget the biology. The Einstapp Fish Tank Stocking Calculator acts as your systematic conscience. It keeps your impulses in check. Whenever Im at the fish accrual and I look something I ”must have,” I tug happening the calculator upon my phone. If it says my tank is at 95% capacity, I put the fish back. Its not virtually having the most fish; its nearly having the healthiest fish. Avoid crowding in your fish tank and you will locate that the goings-on becomes much more relaxing and much less of a chore. No more ”new tank syndrome” every six months. No more constant medicating. Just a clear, vibrant, and successful world under glass. Use the Einstapp Fish Tank Stocking Calculator and realize it right the first time. Your fish will thank youif they could, anyway. Theyll just save swimming happily, which is the deserted thanks a genuine hobbyist needs. Go check your stocking levels right now; you might be amazed at what you find. bigger to be secure than sorry in the world of aquatics. save those filters management and those stocking levels reasonable. praise to a determined tank!
No listing found.

